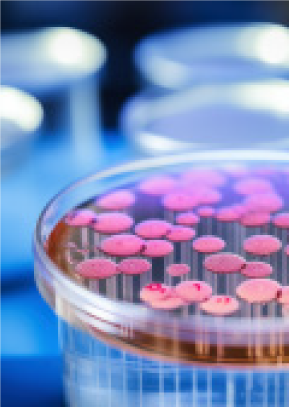

Generator Oxygen
- MEDICAL
- INDUSTRIAL
Generator Oxygen System For Medical
The PSA oxygen generator system uses clean compressed air as raw material and high-quality zeolite molecular sieve as the adsorbent to produce oxygen from the air under a certain pressure. The purified and dried compressed air is adsorbed under pressure and desorbed under reduced pressure in the adsorber. Due to the aerodynamic effect, the diffusion rate of nitrogen in the pores of the zeolite molecular sieve is much greater than that of oxygen. Nitrogen is preferentially adsorbed by the zeolite molecular sleve, and oxygen is enriched in the gas phase to form finished oxygen. Then the pressure is reduced to normal pressure, and the adsorbent desorbs the adsorbed nitrogen and other impurities to achieve regeneration. Generally, two adsorption towers are set up in the system. One tower adsorbs and produces oxygen, and the other tower desorbs and regenerates. The opening and closing of the pneumatic valve is controlled by the PLC program controller to cycle the two towers alternately, thereby obtaining oxygen with higher purity (93 +2%).
• Oxygen capacity: 1~200Nm3/hr (under standard conditions)
• Purity: 93% ± 2% (national standard oxygen content)
• Pressure: normal 0.1~0.55 Mpa (gauge pressure is stable and adjustable) Oxygen dew point: -40°C (normal pressure dew point)
• Online monitoring and display of oxygen purity, flow rate and pressure • Fast start-up speed, qualified oxygen can be provided within 30 minutes • Fully automatic control, enabling unattended operation
• Overall skid-mounted, small footprint, portable installation High purity, capable of purifying 99.5% of aviation oxygen
• Stable operation and low failure rate
• Equipment has low energy consumption and low noise The equipment comes with a sound and light alarm system


To Provide You with the best solution
To provide you with the best solution: aquaculture industry, cutting industry, ozone supporting, sewage treatment, glass blowing, paper industry, wood carbonization, copper pipe welding, biological fermentation, hotel diffusion oxygen supply, cell culture, high altitude oxygen production, ore treatment, carbon sintering, metallurgy and other industries;

Twin tower oxygen generator

Four tower oxygen generator

Box-type oxygen generator

Oxygen filling machine

99.5% high-purity oxygen
Michaeuier nieva notypen production spalum la mainly composed of air compraeston mul portication system, the first stage PGA aeparation device, the secondslag PGA purification devica, control devica, monitoring and alem device. The operation process of the whole system is completaty controlad by PLC, which can realise then automatic operation of one-kay boot
Technical characteristics
- Overall design, skid box structure, mobile, scientific and reasonable layout, small footprint, convenient and fast on-site installation, suitable for Indoor, outdoor, and even in the field Various sites, environmental compatibility is very strong.
- Normal temperature separation, the whole process is a physical process of normal temperature adsorption, high safety.
- Mature technology, high rellability, high efficiency of adsorbent utilization.
- Stable operation, simple structure, parts selected International well-known brands, high quality, long life, less maintenance.
- Advanced technology, energy saving and consumption reduction, according to customer requirements, product oxygen concentration can be selected: 93%+2% or product oxygen concentration greater than 15%
- Simple operation, fast oxygen production, automatic control of the whole process, boot within 3-5 minutes up to 93% ±2% oxygen purity, up to 99% within 15 minutes Oxygen concentration, within 20 minutes can reach 99.5% oxygen concentration, to meet the requirements of rapid gas use.
- Medical grade, oxygen outlet equipped with medical grade precision filter and bactericidal filter, to ensure the generation of oxygen, without any pollutants.
- On-site oxygen storage, rellable oxygen supply. The system can be configured with oxygen booster device, high pressure oxygen cylinder or bus bar device to reserve oxygen during oxygen low period, which can achieve peak peak oxygen supply, temporary maintenance oxygen supply, short-term power off oxygen supply and other functions, providing a strong guarantee for continuous and reliable supply of high-quality medical axygen.


Plateau diffusive oxygen concentrator
The plateau sveicamant le a challenge to human suvkani med han i regulhan lampunct can then hunting the of pornormal. The company le matched des Improving than both isť propía la tha plodnostavna, aldadig thu kar-attitude wevetement, and improving the maygan mendeatier de fan ate in tha regler, Ader enguan-rich vanillation, thin aluatul inciner aftada ka bankow 2000m (including), mut then beter nie maggars sencentration in front by (about 4 14 199). Labor Die skolebach atitude, count of the mutuando ndaleman men dan mendeantud, în armcore the hath of pornovaend and leprosan muric aditetency, as the implementation of megaan supply weglaring he very rom
The main technical characteristics of Zhongsu Hengda Plateau dispersion
1. oxygen supply mode: According to various data show that in order to ensure health and life safety, indoor oxygen enrichment concentration Increased In 4-6% is a suitable choice;
2. oxygen supply time: oxygen supply time and working time is the same;
3. configure the oxygen terminal: the terminal is displayed as the room oxygen concentration (concentration is displayed in Chinese) and can be remote controlled and manually adjusted;
4. the terminal comes with oxygen concentration detection function;
5. intelligent control: can set the concentration value, according to the indoor oxygen concentration automatically start and stop;
6. timing function: can set the running time, timing to automatic shutdown function;
7. oxygen concentration monitoring: equipped with oxygen sensors, real-time online monitoring of Indoor air oxygen concentration, to ensure safety; 8. the whole system is stable, low failure rate;
Main technical indicators:
Oxygen Capacity: 1-200Nm3/hr (under standard condition)
Purity: 93%+2% (standard oxygen content)
Pressure: conventional 0.1~0.55Mpa (adjustable gauge pressure stability)
Oxygen dew point: -40°C (atmospheric dew point)
Main applications: hotels, guesthouses, dormitories, office buildings, residential buildings, plateau tunnel construction sites, border posts, gymnaslums, sports oxygen bars, KTV and other places
Generator Oxygen System For Indrustrial
The PSA oxygen generator system uses clean compressed air as raw material and high-quality zeolite molecular sieve as the adsorbent to produce oxygen from the air under a certain pressure. The purified and dried compressed air is adsorbed under pressure and desorbed under reduced pressure in the adsorber. Due to the aerodynamic effect, the diffusion rate of nitrogen in the pores of the zeolite molecular sieve is much greater than that of oxygen. Nitrogen is preferentially adsorbed by the zeolite molecular sieve, and oxygen is enriched in the gas phase to form finished oxygen. Then the pressure is reduced to normal pressure, and the adsorbent desorbs the adsorbed nitrogen and other impurities to achieve regeneration. Generally, two adsorption towers are set up in the system. One tower adsorbs and produces oxygen, and the other tower desorbs and regenerates. The opening and closing of the pneumatic valve is controlled by the PLC program controller to cycle the two towers alternately, thereby obtaining oxygen with higher purity (93 ±2%).
- Oxygen capacity: 1-200Nm3/hr (under standard conditions)
- Purity: 93% ± 2% (national standard oxygen content)
- Pressure: normal 0.1~0.55 Mpa (gauge pressure is stable and adjustable)
- Oxygen dew point: <-40°C (normal pressure dew point)
- Online monitoring and display of oxygen purity, flow rate and pressure
- Fast start-up speed, qualified oxygen can be provided within 30 minutes
- Fully automatic control, enabling unattended operation
- Overall skid-mounted, small footprint, portable installation
- High purity, capable of purifying 99.5% of aviation oxygen
Stable operation and low failure rate
- Equipment has low energy consumption and low noise
- The equipment comes with a sound and light alarm system


To Provide You with the best solution
To provide you with the best solution: aquaculture industry, cutting industry, ozone supporting, sewage treatment, glass blowing, paper industry, wood carbonization, copper pipe welding, biological fermentation, hotel diffusion oxygen supply, cell culture, high altitude oxygen production, ore treatment, carbon sintering, metallurgy and other industries;
Twin tower oxygen generator

Four tower oxygen generator

Box-type oxygen generator

Oxygen filling machine

99.5% high-purity oxygen
Michaeuier nieva notypen production spalum la mainly composed of air compraeston mul portication system, the first stage PGA aeparation device, the secondslag PGA purification devica, control devica, monitoring and alem device. The operation process of the whole system is completaty controlad by PLC, which can realise then automatic operation of one-kay boot
Technical characteristics
- Overall design, skid box structure, mobile, scientific and reasonable layout, small footprint, convenient and fast on-site installation, suitable for Indoor, outdoor, and even in the field Various sites, environmental compatibility is very strong.
- Normal temperature separation, the whole process is a physical process of normal temperature adsorption, high safety.
- Mature technology, high rellability, high efficiency of adsorbent utilization.
- Stable operation, simple structure, parts selected International well-known brands, high quality, long life, less maintenance.
- Advanced technology, energy saving and consumption reduction, according to customer requirements, product oxygen concentration can be selected: 93%+2% or product oxygen concentration greater than 15%
- Simple operation, fast oxygen production, automatic control of the whole process, boot within 3-5 minutes up to 93% ±2% oxygen purity, up to 99% within 15 minutes Oxygen concentration, within 20 minutes can reach 99.5% oxygen concentration, to meet the requirements of rapid gas use.
- Medical grade, oxygen outlet equipped with medical grade precision filter and bactericidal filter, to ensure the generation of oxygen, without any pollutants.
- On-site oxygen storage, rellable oxygen supply. The system can be configured with oxygen booster device, high pressure oxygen cylinder or bus bar device to reserve oxygen during oxygen low period, which can achieve peak peak oxygen supply, temporary maintenance oxygen supply, short-term power off oxygen supply and other functions, providing a strong guarantee for continuous and reliable supply of high-quality medical axygen.


Plateau diffusive oxygen concentrator
The plateau sveicamant le a challenge to human suvkani med han i regulhan lampunct can then hunting the of pornormal. The company le matched des Improving than both isť propía la tha plodnostavna, aldadig thu kar-attitude wevetement, and improving the maygan mendeatier de fan ate in tha regler, Ader enguan-rich vanillation, thin aluatul inciner aftada ka bankow 2000m (including), mut then beter nie maggars sencentration in front by (about 4 14 199). Labor Die skolebach atitude, count of the mutuando ndaleman men dan mendeantud, în armcore the hath of pornovaend and leprosan muric aditetency, as the implementation of megaan supply weglaring he very rom
The main technical characteristics of Zhongsu Hengda Plateau dispersion
1. oxygen supply mode: According to various data show that in order to ensure health and life safety, indoor oxygen enrichment concentration Increased In 4-6% is a suitable choice;
2. oxygen supply time: oxygen supply time and working time is the same;
3. configure the oxygen terminal: the terminal is displayed as the room oxygen concentration (concentration is displayed in Chinese) and can be remote controlled and manually adjusted;
4. the terminal comes with oxygen concentration detection function;
5. intelligent control: can set the concentration value, according to the indoor oxygen concentration automatically start and stop;
6. timing function: can set the running time, timing to automatic shutdown function;
7. oxygen concentration monitoring: equipped with oxygen sensors, real-time online monitoring of Indoor air oxygen concentration, to ensure safety; 8. the whole system is stable, low failure rate;
Main technical indicators:
Oxygen Capacity: 1-200Nm3/hr (under standard condition)
Purity: 93%+2% (standard oxygen content)
Pressure: conventional 0.1~0.55Mpa (adjustable gauge pressure stability)
Oxygen dew point: -40°C (atmospheric dew point)
Main applications: hotels, guesthouses, dormitories, office buildings, residential buildings, plateau tunnel construction sites, border posts, gymnaslums, sports oxygen bars, KTV and other places

Advanced process reduces energy consumption and produces high-purity nitrogen
Pressure swing adsorption nitrogen generator (referred to as PSA nitrogen generator) is a device that uses molecular sieve as adsorption material and produces nitrogen based on the principle of pressure swing adsorption. The nitrogen generator is composed of three systems: compressed air system, air purification system, PSA nitrogen generator system, etc.;
Nitrogen generator flowchart

Product principle
It uses clean compressed air as raw material and uses carbon molecular sieve as the adsorbent. According to the difference in the adsorption amount of oxygen and nitrogen in the air on the surface of the carbon molecular sieve and the difference in the diffusion rate of oxygen and nitrogen In the carbon molecular slave, it is controlled by a programmable controller. The opening and closing of the programmable valve realizes the process of pressure adsorption and decompression desorption, completes the separation of oxygen and nitrogen, and obtains nitrogen of the required purity.
• Nitrogen flow rate: 1-3000Nm3/hr
• Purity: 95%-99.9995%
• Pressure: 0~0.65 Mpa adjustable (regular), other pressures can be realized according to requirements
• Normal pressure dew point: <-40°°C (normal)
• High nitrogen purity, up to 99.9995%High nitrogen purity, up to 99.9995% • Fast start-up speed, qualified nitrogen can be provided within 30 minutes • Nitrogen purity, flow, and pressure can be monitored and displayed online
• Fully automatic control, enabling unattended operation
• Overall skid-mounted, small footprint, portable installation
• Pressure and dew point can be customized on demand, up to −70°C
Application
Petrochemical Industry, plastic products, petroleum storage tanks and container replacement and cleaning, pipeline purging, oll tanker platforms, rubber packaging and tire production protection, rubber paint, rosin, resin protective gas, synthetic fiber drawing, nitrogen filling and anti-oxidation, dry quenching Coking, desulfurization, bright annealing, powder sintering, laser cutting, reflow soldering, laser welding, photovoltaic Industry, 3D printing, lithium batteries, chromatography, mass spectrometer, coal mine, semiconductor chip, pharmaceutical raw materials, drug nitrogen-filled packaging and transportation, cosmetics, charging Nitrogen controlled storage of food, granaries, etc.

HDFC series carbon purification nitrogen generator
Based on the principle of O,+C-CO,(CO), this method uses highly active carbon-supported reactants to react at a certain temperature to generate CO, remove oxygen, and generate 99.9999% high-purity nitrogen. This process consists of two or more reactors working alterately to continuously produce gas. It is suitable for sites with gas volume 500Nmh and no high requirements for CO, and CO.
- Nitrogen volume: 1-500Nmh;
- Purity: >99.999%;
- Normal pressure dew point: <-70°C;
1. Nitrogen has high purity, with the highest purity reaching over 99.9995%;
2. Nitrogen purity, flow rate and pressure can be monitored and displayed online;
3. Nitrogen dew point is stable and can reach <-70C;
4. The overall device has low power consumption and stable operation.

HDFC series hydrogen purification nitrogen generator
This method is based on the principle of 2 02+H2→2HO2, using a catalyst reagent to react at a certain temperature to generate HO2, remove oxygen, and generate >99.999% high-purity nitrogen. This process consists of two or more reactors working alternately to continuously produce gas. It is suitable for sites with gas volume 500Nm3/h and no high requirements for H2.
- Nitrogen volume: 1-500Nm3/h;
- Purity: >99.999%;
- Normal pressure dew point: <-70°C;
1. Nitrogen has high purity, with the highest purity reaching over 99.9995%;
2. Nitrogen purity, flow rate and pressure can be monitored and displayed online;
3. Nitrogen dew point is stable and can reach <-70°C;
4. The overall device has low power consumption and stable operation.

Integrated skid-mounted nitrogen generator

Case Type oxygen generator equipment

Trailer type nitrogen generator

Technical selection parameter

Nitrogen filling equipment






Ammonia decomposition hydrogen production unit
1. 2NH,——-3H, + N2
2.The HDAQ series of ammonia decomposition hydrogen generation units uses liquid ammonia as the raw material, and the gas is decomposed under the action of a catalyst to produce a mixture of hydrogen at 75%, and nitrogen at 25%. The purity of the hydrogen gas can be further Increased to 99.999% through the process of pressure swing adsorption.
The U-shaped or star-shaped monolithic cracking furnace tubes make the gas flow uniform in all parts of the furnace, resulting in equal service life and maximum utilization of heat efficiency through the use of an external hanging wire structure.
The heat exchanger adopts a coll structure, which has a larger heat exchange area to ensure the full utilization of heat efficiency, and at the same time, it guarantees a long service life.
Unique material
The furnace material la a rare high-temperature heat-realstant alloy material, which ensures a long service life in high-temperature and highly corrosive environments. The heating element is made of nickel-chromium alloy with excellent mechanical properties at high temperatures, and Its surface load is determined to be within a reasonable range. The core Insulation material aluminum allicata fiber la formed by vacuum suction filtration and reinforced on the surface more than five times, so it la light and has high strength; at the same time, its unique structure determines that the material coefficient is 15% lower than similar products.
• The principle is simple, the structure is compact, the area is small, and the operation is easy;
• Low investment, low energy consumption and low operating costs;
• Wide range of applications, meeting most hydrogen usage needs; • The core components of the furnace body, furnace bladder and heating wire are optimized and have a three-year warranty under normal working conditions;
• Used in conjunction with a gas purification device, high purity pro tective gas can be obtained.
Applications: oil-free bearings, powder metallurgy, bright annealing, sintering of electronic materials, sintering of high-temperature refractory materials, chemical industry, tin bath protective gas in float glass production, ceramic industry

Circular furnace ammonia decomposition equipment


Liquid ammonia vaporizer
he principle of ammonia vaporizer is a device that vaporizes liquid ammonia Into gaseous ammonia under the heating of warm water vapor In the water leg. In brief, it is a process in which liquid ammonia with a boiling point of -33″ C is heated by warm water vapor in the water leg and vaporized to become gaseous ammonia; the heating is Indirect (steam heating type, hot water heating type, high temperature heat exchange type); the structure of the vaporizer is simple and reliable, and the operation effect is good and the output pressure is stable; the automatic carry position of the vaporizer can be set at will. Accessories Include an ammonia pressure gauge, an ammonia safety valve, a liquid level gauge, a sewage discharge room (thermometer optional), etc.

The hydrogen purification device is a device used in conjunction with the ammonia decomposition gas generation device. It can also be a thermal regeneration drying and purification device for other gases. It can remove the moisture and residual content in the ammonia decomposition mixed gas, and can deeply dehydrate and dry hydrogen, helium, oxygen and other gases.
The raw material gas enters a set of adsorbers, is adsorbed and dried and sent to the point of use through the filter. Take a trace amount of product gas and regenerate the adsorbed saturated molecular sieves in another set of adsorbers at a temperature of 250 C-300 C. The two sets of adsorbers work and regeneration is performed alternately. Continuous and stable product gas can be obtained.
- Gas processing volume: 1-3000Nm3/h,
- Pressure: 0.8Mpa
- Gas purity: >99.9995%
- Dew point: -60°C
1. The process is simple and low-cost. Because of the use of atmospheric pressure thermal regeneration process, the process of high-pressure purification is eliminated, it can also remove residual ammonia and water impurities.
2. Simple structure and reliable performance.
3. Because of the double tower adsorption process and the long adsorption drying and regeneration cycle, continuous high-purity gas can be obtained. 4. The dew point of the product gas is good and stable, and can be detected online by a dew point meter.
Pipes, wires and plates used in the ferrous metallurgical industry. Annealing process of precision mechanical parts such as bearings in the machinery industry. Used in float glass production lines and in powder metallurgy sintering processes. Used in chemical hydrogenation reduction process and nanomaterial processing.

Process flow diagram of protective gas station system
The protective gas station is composed of a pressure swing adsorption (PSA) nitrogen production device, a nitrogen purification device, an ammonia decomposition hydrogen production device, a liquid ammonia storage tank device, a hydrogenation, deoxygenation and boosting device, a hydrogen-nitrogen proportioning device, and a liquid ammonia storage device.. It can adjust the system configuration of the protective gas station according to the requirements of the on-site process. Can be easily combined. To reduce customer investment fees and usage costs. It is mainly used for hot-dip galvanizing, nickel plating and copper processing of powder metallurgy steel strips.

Hydrogen nitrogen ratio device (Figure 1)
The nitrogen and hydrogen proportioning device mainly controls the flow rate of hydrogenation or nitrogen addition to achieve the purpose of mixing hydrogen and nitrogen in a certain proportion. Under normal circumstances, it is to control the flow of gas with a small content. A nitrogen and hydrogen proportioning device mainly consists of a nitrogen flow meter, a hydrogen flow meter, a mixed gas flow meter, a hydrogen analyzer, a PID controller, a flow regulating valve, and a pressure gauge., mixing tank, chassis, etc.
The hydrogen analyzer measures the hydrogen content in the mixing tank. The hydrogen analyzer converts the measured content into a 4 ~ 20mA signal and transmits it to the PID controller. The PID controller converts this signal into a mechanical signal to the flow control valve. Issue an action command to direct the opening of the flow regulating valve. The opening of the flow regulating valve determines the hydrogen content in the mixing tank. It is continuously adjusted to achieve the purpose of mixing hydrogen and nitrogen in a certain proportion.
(1) It is equipped with an audible and visual alarm device for the
upper and lower limits of hydrogen excess.
(2) When the online hydrogen content exceeds the set index, the hydrogenation pipeline will be automatically cut off.
(3) There is a manual hydrogenation pipeline, which can be used under special circumstances to ensure the operation of the entire device. (4) Designed with ultra-high and low-pressure sound and light alarm devices
RX gas generator (Figure 2)
RX gas generator (Figure 2)
The gas production principle of the RX gas generator is to mix natural gas and air in a certain proportion, and then prepare RX gas through an externally heated reaction tank equipped with a catalyst. The main components of the RX gas generated after the raw gas is mixed, cracked, cooled and other processes are CO, H2, N, and trace amounts of H2O, CO2, CH4, O2, etc. The RX gas generator structure of Suzhou Hengda Purification Equipment Co., Ltd. consists of the following parts: raw gas supply and mixing system, cracking device, product gas cooling device, RX gas output system, detection instruments and control system.

